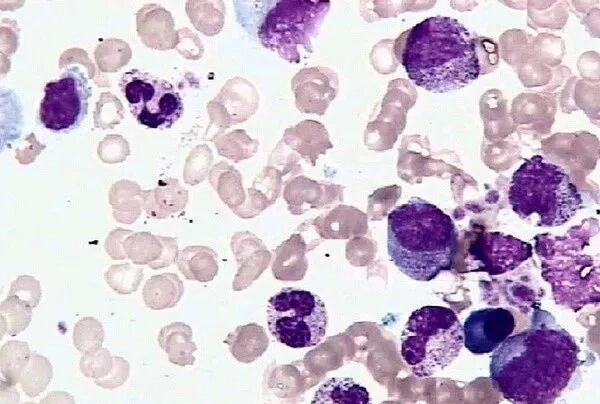

肺纤维化(Pulmonary fibrosis)是以成纤维细胞增殖及大量细胞外基质聚集并伴炎症损伤、组织结构破坏为特征的一大类肺疾病的终末期改变,也就是正常的肺泡组织被损坏后经过异常修复导致结构异常(疤痕形成)。特发性间质性肺炎(IIP)中最常见的以肺纤维化病变为主要表现形式的疾病类型为特发性肺纤维化(IPF),是一种能导致肺功能进行性丧失的严重的间质性肺疾病。在我国,特发性肺纤维化发病率和死亡率逐年增加,诊断后的平均生存期仅2.8年,死亡率高于大多数肿瘤,被称为一种“类肿瘤疾病”。

引发肺纤维化的原因
呼吸困难是肺纤维化最常见症状。轻度肺纤维化时,呼吸困难常在剧烈活动时出现,因此常常被忽视或误诊为其他疾病。高危因素有:吸烟、环境暴露、病毒感染、胃食管反流、遗传因素等原因导致。

肺纤维化症状表现
轻度肺纤维化时,呼吸困难常在剧烈活动时出现。当肺纤维化进展时,在静息时也发生呼吸困难,严重的肺纤维化患者可出现进行性呼吸困难。部分患者有杵状指和发绀。干咳、乏力、呼吸短促、尤其是劳累;慢性干燥、咳嗽、疲劳虚弱胸部不适包括胸痛;食欲不振,体重迅速减;肺纤维化表现为进行性呼吸短促;在听诊时,肺基部有时会听到精细的吸气性噼啪声。

传统方式治疗肺纤维化
1、药物治疗:在我国目前已被国家药监局批准的用于特发性肺纤维化治疗的药物仅有一个,即艾思瑞(化学名:吡非尼酮)。目前对吡非尼酮的认识还有限,且无论在欧洲还是亚洲使用此药价格都较高。目前此药已在临床上使用,但没有报道示其能明显改善患者的症状或生活质量。
2、非药物治疗:①氧疗;②机械通气;③肺康复;④ 肺移植。

利用干细胞治疗肺纤维化
因肺纤维化病因复杂且严重危害人类健康,传统临床治疗效果差。近年来,具有多向分化、免疫调节和旁分泌特征的间充质干细胞治疗引起了广泛的关注。间充质干细胞具有免疫原性低、归巢定植、免疫-炎症调节、分化、旁分泌等特征。在《中华结核和呼吸杂志》刊文。通过观察间充质干细胞对大鼠肺纤维化动物模型的影响,探讨治疗肺纤维化的新方法。证实外源给予的间充质干细胞可以减轻肺纤维化的形成,在肺损伤早期给予MSC干预的疗效更好。在《中国呼吸与危重监护杂志》刊文,间充质干细胞对博莱霉素A5(BLMA5)所致的大鼠肺间充质纤维化的治疗作用。间充质干细胞可治疗损伤肺组织,并能有效阻止BLMA5诱导的大鼠肺纤维化,且早期治疗效果优于晚期。
干细胞治疗肺纤维化治疗原理
抗氧化机制:
间充质干细胞具有一定的抗氧化和清除氧自由基的作用,有助于肺纤维化的减轻。
细胞融合、细胞间相互作用、分化、促进血管新生:这些机制或单独或相互作用,都将发挥抗纤维化作用。
抗炎和免疫调节机制:
间充质干细胞通过分泌抗炎因子和抗菌多肽或者抑制促炎信号通路、上调炎症信号通路和细菌的吞噬作用等发挥抗炎的免疫调节作用,减轻肺纤维化。
旁分泌机制:
间充质干细胞分泌诸多因子,包括肝细胞生长因子、血管生成素-1、血管内皮细胞生长因子、某些趋化因子、炎症因子和调节肽等,直接或间接减轻肺内炎症反应和肺纤维化。
干细胞分化成新肺脏细胞后,可以恢复肺脏功能。在放射性肺损伤中,干细胞还可以减少炎症渗出,减轻肺纤维化形成,修复受损肺脏细胞恢复肺脏功能发挥作用。
上海本正生物工程有限公司提供的干细胞是从脐带、胎盘中提取的一种修复器官机理的未完全分化的原始细胞,具有自我更新、多项分化和高度繁殖的能力,医学上称为“万能细胞”,它是形成人体各种组织器官的起源细胞。干细胞对临床上一些疑难疾病的治疗如:脑瘫、老年痴呆、脑萎缩、帕金森病、中风、肝硬化、糖尿病、红斑狼疮、股骨头坏死、软骨和关节损伤、心脏和脊髓损伤等,取得显著效果,它拥有更加鲜活细胞能量,可以快速、有效进入体内,分泌多种有益细胞因子,调节体内微环境,激活干细胞再生能力,重启时光之门,追溯青春绽放源头,实现对人体衰老状态减缓,同时有效改善身体亚健康以及预防肿瘤发生。

|
